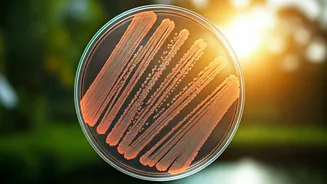
Kerala's Search for a State Bacterium: A New Scientific Frontier

Sankranti's Sweet Embrace
Til-Gur, a sweet concoction of sesame seeds (til) and jaggery (gur), embodies the spirit of the Sankranti festival. This traditional sweet isn't just a treat;
it's a symbolic offering. The sesame seeds represent the warmth of the sun and the beginning of longer days, while jaggery symbolizes sweetness and prosperity. During Sankranti, people exchange Til-Gur with loved ones, symbolizing a wish for sweet beginnings and harmonious relationships. This simple act of sharing becomes a communal gesture of goodwill. Each bite signifies the desire for positivity in the coming year, reminding everyone of the joys associated with this auspicious occasion. The tradition serves as a reminder to appreciate the gifts of nature and the blessings of community.
Seasonal Eating's Wisdom
The popularity of Til-Gur highlights the intelligence of seasonal eating. The ingredients, sesame seeds, and jaggery, are traditionally available during this time of the year. This practice aligns with nature's rhythm, helping people benefit from the seasonal bounty. Consuming Til-Gur during Sankranti ensures that the body receives nutrients that are abundant during winter. It is said that sesame seeds keep the body warm during the colder months, while jaggery helps boost immunity. This mindful approach to food reflects a deep understanding of how specific foods support health during different times of the year. The tradition of consuming Til-Gur shows how food choices can be aligned with nature and improve overall well-being. It is a testament to traditional practices that emphasize the harmonious relationship between humans and their environment.
Sweet Traditions' Relevance
Despite changing times, Til-Gur's significance remains strong. It continues to be an integral part of Sankranti celebrations across India. Its enduring popularity stems from its delicious taste, but also because it is a connection to culture. Each bite evokes memories of celebrations. Families often come together to make Til-Gur, passing down recipes and traditions through generations. This act of preparation and sharing reinforces family bonds and strengthens cultural identity. The widespread consumption of Til-Gur is a reminder of the value of preserving traditions. It is a celebration of the country’s diverse heritage, and also a testament to the power of food to bring people together. The continued presence of Til-Gur on the Sankranti table ensures that these values are passed on to future generations.